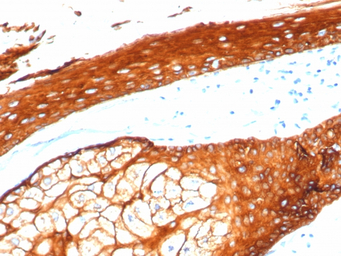
产品细节图片1

相关产品推荐更多 >
万千商家帮你免费找货
0 人在求购买到急需产品
- 详细信息
- 文献和实验
- 技术资料
- 免疫原:
Synthetic peptide corresponding to human Type II Cytokeratins residues within aa300-400
- 亚型:
IgG
- 形态:
Liquid
- 保存条件:
Store as concentrated solution. Centrifuge briefly prior to opening vial. Store at 4ºC.
- 克隆性:
Monoclonal
- 标记物:
Unconjugated
- 适应物种:
Human
- 保质期:
12 months from the shipping date of the product.
- 抗原来源:
Human
- 目录编号:
GTX02665
- 级别:
Primary Antibodies
- 库存:
Available
- 供应商:
GeneTex
- 宿主:
Rabbit
- 应用范围:
IHC-P
- 浓度:
200 μg/ml (Please refer to the vial label for the specific concentration.)
- 靶点:
This antibody can detect high molecular weight CK1, CK2, CK3, CK4, CK5, CK6, CK7 and CK8.
- 抗体英文名:
Cytokeratin 2 antibody [KRTH/4392R]
- 抗体名:
Cytokeratin 2 抗体 [KRTH/4392R]
- 规格:
100 μg
IHC-P analysis of human skin tissue section using GTX02665 Cytokeratin 2 antibody [KRTH/4392R].

IHC-P analysis of human skin tissue section using GTX02665 Cytokeratin 2 antibody [KRTH/4392R].
风险提示:丁香通仅作为第三方平台,为商家信息发布提供平台空间。用户咨询产品时请注意保护个人信息及财产安全,合理判断,谨慎选购商品,商家和用户对交易行为负责。对于医疗器械类产品,请先查证核实企业经营资质和医疗器械产品注册证情况。
 文献和实验
文献和实验上皮及间皮类常用标记抗体EPITHELIAL AND MESOTHELIAL MARKERSCK (MNF 116)- MNF-116 is a pan-cytokeratin antibody.- Source: Dakopatts.- Dilution 1:50.- Antigen retrieval method: HIER (pressure cooking) using EDTA.- Staining pattern: Cytoplasmic, typically
Immunocytochemical Detection and Characterisation of Individual Micrometastatic Tumour Cells
. This chapter describes a robust reliable system for the immunochemical detection of individual micrometastatic tumour cells from the BM aspirates of patients with solid epithelial tumours, based on the binding of antibody to cytokeratin proteins.
Fluorescent Immunohistochemistry and In Situ Hybridization Analysis of Pancreas
is always required for different tissues and antigens. Using a low-power antigen retrieval technique, with appropriate dilution of antibodies, we successfully immunostained key antigens in the pancreas such as insulin, PDX-1, glucagon, cytokeratin, and CD
 技术资料
技术资料暂无技术资料 索取技术资料






![PSMA antibody [GCP-05] (PE)](https://img1.dxycdn.com/2022/0328/219/2748776190306500453-14.jpg!wh200)

![Calponin antibody [CALP (hCP)]](https://img1.dxycdn.com/2022/0328/701/8052735837748300453-14.jpg!wh200)
![CBWD1 antibody [N2C3]](https://img1.dxycdn.com/2022/0328/273/4503846300473300453-14.jpg!wh200)
